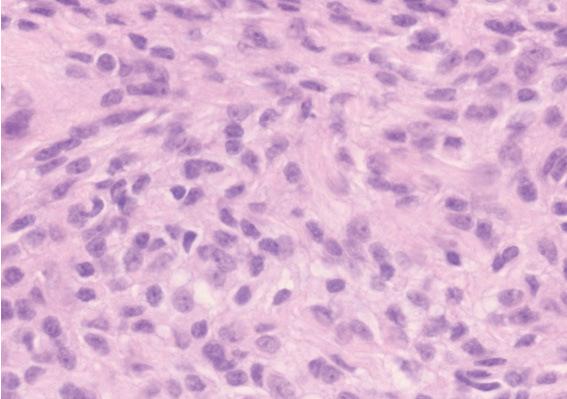

伴有恶性转化和远处转移的脊髓内脑膜瘤。
Intraspinal meningioma with malignant transformation and distant metastasis.
作者信息
Ito Kenyu, Imagama Shiro, Ando Kei, Kobayashi Kazuyoshi, Shido Yoji, Go Yoshida, Arima Hideyuki, Kanbara Shunsuke, Hirose Takanori, Matsuyama Yukihiro, Nishida Yoshihiro, Ishiguro Naoki
机构信息
Department of Orthopaedic Surgery, Nagoya University Graduate School of Medicine, Nagoya, Japan.
Department of Orthopaedic Surgery, Hamamatsu University School of Medicine, Hamamatsu, Japan.
出版信息
Nagoya J Med Sci. 2017 Feb;79(1):97-102. doi: 10.18999/nagjms.79.1.97.
Meningioma is typically considered to be a benign tumor. Malignant transformation and metastasis of meningiomas are rare. Moreover, most meningiomas are intracranial, and there are few reports on intraspinal meningiomas. This report aimed to describe the clinical features and pathological findings of a case of malignant transformation and distant metastasis of intraspinal meningioma, with a review of the literature. A 44-year-old man with a bilateral lower limb paresis was diagnosed with an intradural extramedullary tumor of the thoracic spine. Primary tumor resection was performed, and the histological findings revealed atypical meningioma. The meningioma recurred 2 years after the primary surgery, and a second resection was performed, but only partial resection was possible because of decreased motor evoked potential. At age 48, the patient's lower limb weakness returned, and a third resection was performed, and the histological finding remained atypical meningioma. At age 54, the tumor increased and stereotactic irradiation was performed. At age 60, the patient was diagnosed with metastatic tumors of the rib, lumbar vertebra, cervical spine, and sacrum. Biopsy of the rib metastatic tumor was performed, and the histological findings revealed anaplastic meningioma. This case is the first report of an intraspinal meningioma that transformed from atypical to anaplastic meningioma with distant hematogenous metastasis.
脑膜瘤通常被认为是一种良性肿瘤。脑膜瘤的恶性转化和转移很少见。此外,大多数脑膜瘤位于颅内,关于脊髓内脑膜瘤的报道较少。本报告旨在描述一例脊髓内脑膜瘤恶性转化并远处转移的临床特征和病理结果,并对文献进行综述。一名44岁双侧下肢麻痹的男性被诊断为胸段脊柱硬脊膜外髓外肿瘤。进行了原发肿瘤切除术,组织学检查结果显示为非典型脑膜瘤。脑膜瘤在初次手术后2年复发,进行了二次切除,但由于运动诱发电位降低,只能进行部分切除。48岁时,患者下肢无力复发,进行了第三次切除,组织学检查结果仍为非典型脑膜瘤。54岁时,肿瘤增大,进行了立体定向放射治疗。60岁时,患者被诊断为肋骨、腰椎、颈椎和骶骨转移瘤。对肋骨转移瘤进行了活检,组织学检查结果显示为间变性脑膜瘤。该病例是首例脊髓内脑膜瘤从非典型转变为间变性脑膜瘤并发生远处血行转移的报道。